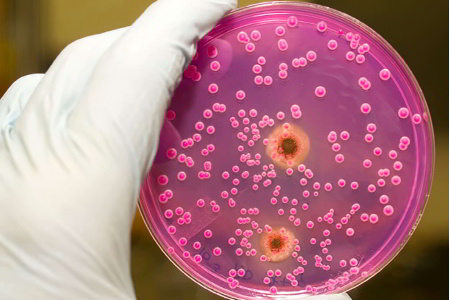

Что такое молочница у женщин?
Молочница у женщин — это заболевание влагалища, известное как кандидоз. Оно получило свое название из-за белых выделений, напоминающих по текстуре творог.
Основным возбудителем молочницы является грибок Candida albicans. Исследования показывают, что этот микроорганизм присутствует в организме около 80% людей как часть нормальной микрофлоры и обычно не вызывает проблем. Влагалище женщины не стерильно; на его эпителии обитают различные микроорганизмы, включая грибок Candida. Он играет важную роль в поддержании нормального уровня pH влагалища, что критично для здоровья эпителия и процесса оплодотворения.
Нормальная флора влагалища также помогает противостоять нежелательным микроорганизмам, снижая риск инфекционных заболеваний. Иммунная система женщины контролирует состояние микрофлоры и подавляет избыточное размножение «своих» бактерий. Если по каким-либо причинам этот контроль ослабевает или создаются условия для активного размножения грибка, вероятность развития молочницы значительно возрастает.
Врачи отмечают, что молочница, или кандидоз, является распространенной грибковой инфекцией, вызванной избыточным размножением грибов рода Candida. Основными причинами возникновения заболевания могут быть гормональные изменения, стресс, ослабление иммунной системы, а также неправильное питание и прием антибиотиков. Симптомы молочницы у женщин включают зуд и жжение в области влагалища, белые творожистые выделения с кислым запахом, а также дискомфорт во время полового акта и мочеиспускания. Важно, что при появлении таких признаков необходимо обратиться к врачу для диагностики и назначения адекватного лечения, так как игнорирование симптомов может привести к хронической форме заболевания. Врачи подчеркивают, что профилактика, включая соблюдение гигиенических норм и поддержание иммунной системы, играет ключевую роль в предотвращении молочницы.

Причины возникновения молочницы у женщин
Существует множество факторов, способных нарушить хрупкое равновесие в женском организме и способствовать возникновению молочницы.
- Прием антибиотиков — одна из наиболее распространенных причин. Многие заболевания лечатся антибиотиками, которые эффективно устраняют опасные инфекции. Однако эти препараты могут негативно сказаться на естественной микрофлоре влагалища, так как действуют не выборочно.
- Грибки имеют иную структуру клеточной стенки, и противомикробные антибиотики для них не опасны. В результате грибки, вызывающие молочницу, остаются нетронутыми, а бактерии страдают и частично погибают. В природе не бывает пустых ниш, и место погибших микробов занимает Candida albicans, у которой нет конкурентов. В итоге у женщины развивается кандидоз.
- Снижение иммунной защиты также играет важную роль, так как именно иммунитет сдерживает рост условно патогенной флоры. Кандидоз является наиболее распространенной оппортунистической инфекцией среди пациентов с ВИЧ. У таких пациентов кандидоз может проявляться в нескольких местах (ротовая полость, влагалище, кишечник) и плохо поддаваться лечению, что может указывать на наличие ВИЧ. Хронические воспалительные заболевания и длительные бактериальные инфекции также негативно влияют на иммунную систему.
- Нарушение обмена веществ часто связано с сахарным диабетом. При этом заболевании не только нарушается уровень сахара, но и страдают жировой и белковый обмены. Сахарный диабет способствует развитию кандидоза по нескольким причинам.
- При недостаточном контроле со стороны пациента (прием препаратов или инсулина, мониторинг уровня глюкозы) в крови накапливается много углеводов. Это отражается на их содержании в межклеточном пространстве и в слизистой влагалища. В результате бактерии и грибок Candida albicans оказываются в сладкой среде, что создает идеальные условия для их размножения и увеличивает риск молочницы.
- Иммуноглобулины — это вещества, обеспечивающие иммунный ответ организма. Нарушение белкового обмена при сахарном диабете негативно сказывается на их образовании, что приводит к снижению иммунитета и отсутствию контроля над состоянием микрофлоры. Грибки активно используют эту ситуацию, размножаясь в благоприятной среде и вызывая кандидоз.
- Несбалансированное питание — человеку необходимо получать белки, жиры и углеводы в определенных пропорциях. Многие женщины увлекаются сладостями и потребляют слишком много сахара, мучных изделий и сладких напитков. Поджелудочная железа не всегда справляется с выработкой инсулина для поддержания уровня глюкозы в норме. В результате возникает ситуация, аналогичная сахарному диабету: высокий уровень сахара в крови приводит к его накоплению в эпителии влагалища, создавая благоприятные условия для размножения Candida albicans. Кроме того, у любителей сладкого повышается риск развития сахарного диабета второго типа, что гораздо серьезнее и опаснее, чем молочница.
- Гормональный фон также существенно влияет на состояние половых органов женщины, включая влагалище.
- Беременность может вызвать значительные изменения в гормональном фоне, что увеличивает риск молочницы.
- Неправильно подобранные гормональные контрацептивы могут изменить уровень гормонов в организме, что также повышает вероятность кандидоза.
- Различные заболевания эндокринной системы могут способствовать развитию молочницы. Опытные врачи всегда учитывают этот фактор и стараются выявить первопричину, что позволяет не только предотвратить кандидоз в будущем, но и устранить гормональные нарушения.
- Ношение тесного синтетического нижнего белья или неправильное использование гигиенических прокладок (которые нужно менять достаточно часто) создает условия, при которых тепло и влага не могут выйти наружу, что является идеальной средой для размножения грибков.
| Причина | Признаки | Симптомы |
|---|---|---|
| Дисбаланс вагинальной микрофлоры (снижение уровня лактобацилл, увеличение уровня грибов рода Candida) | Изменение цвета и консистенции вагинальных выделений (белые, творожистые) | Зуд и жжение во влагалище и вульве |
| Прием антибиотиков | Характерный запах выделений (кислый) | Боль при мочеиспускании |
| Снижение иммунитета | Покраснение и отек наружных половых органов | Дискомфорт во время полового акта |
| Сахарный диабет | Наличие белых пятен на слизистой влагалища | Частые рецидивы молочницы |
| Беременность | Ощущение сухости во влагалище | Трещины в уголках губ (ангулярный стоматит — в редких случаях) |
| Несоблюдение правил личной гигиены | Выделения могут распространяться на область промежности | Общие признаки недомогания (слабость, головная боль — в редких случаях) |
| Тесная синтетическая одежда | ||
| Стресс |
Симптомы молочницы у женщины
Заболевание имеет характерные признаки, что позволяет врачам быстро установить диагноз. Часто женщины уже до визита к специалисту догадываются о своей проблеме и пытаются справиться с ней самостоятельно, что крайне нежелательно.
Для молочницы характерны следующие симптомы:
- Творожистые выделения из наружных половых органов. Особенно заметны на тёмном нижнем белье. Это слизь с множеством белых комочков.
- Зуд и жжение в области влагалища. Не следует сильно чесать поражённую область, так как это может повредить воспалённый эпителий и создать условия для проникновения инфекции в глубокие слои тканей. Кроме того, расчёсывание может распространить выделения на большую площадь, вызывая дополнительное воспаление.
- Боль и дискомфорт при мочеиспускании. Это связано со снижением защитных свойств слизи влагалища и уретры. Эпителий становится уязвимым перед мочой, а воспаление усиливает чувствительность рецепторов.
- Боль и жжение во время полового акта. Это одна из причин, по которой следует воздержаться от интимной близости до полного выздоровления.
- Запах. Он не слишком выражен и имеет кисловатый оттенок («кефирный»). Обычно его ощущает только женщина, но это может стать серьёзной проблемой. Пациентки часто считают, что окружающие могут его уловить. Многие венерические заболевания и бактериальный вагиноз сопровождаются неприятным запахом, но он не имеет отношения к молочнице.
При стертом (атипичном) течении молочницы и слабо выраженных симптомах женщины могут испытывать лишь один из перечисленных признаков. В таких случаях диагностировать заболевание без помощи специалиста невозможно. Кандидоз часто сопутствует различным гинекологическим заболеваниям, включая скрытые и опасные инфекции, передающиеся половым путём. Только опытный врач может проанализировать симптомы и назначить адекватное лечение. Самодиагностика в тяжёлых случаях неэффективна, а самолечение может быть опасным.
Сравнительную таблицу симптомов для молочницы, бактериального вагинита и трихомониаза можно увидеть ниже. Однако не стоит рассматривать её как инструмент для диагностики. Диагноз устанавливает врач на основе анализов, осмотра и жалоб пациента. Даже в таких случаях не исключено наличие других половых инфекций, которые могут сопутствовать молочнице. Самолечение недопустимо. Все назначения должен делать лечащий врач.
| Молочница | Запах: Кисловатый Выделения: Гомогенные, густые молочного цвета, напоминающие творог Дискомфорт: Жжение, зуд, боли во время полового акта и при мочеиспускании |
| Трихомониаз | Запах: Неприятный рыбный запах Выделения: Обильные, гнойные, пенистые желтовато-зелёного оттенка Дискомфорт: Интенсивный нарастающий зуд (наружный и внутренний), нарушение мочеиспускания, покраснение (раздражение) слизистой влагалища. |
| Бактериальный вагинит | Запах: Запах рыбы (характерно для выделений) Выделения: Обильные и жидкие серо-белого цвета, иногда пенистые Дискомфорт: Вагинальный зуд, жжение, раздражение слизистой. |
Молочница, или кандидоз, вызывает у женщин множество вопросов и опасений. Многие отмечают, что основным признаком является зуд и жжение в области влагалища, что значительно ухудшает качество жизни. Женщины также сообщают о белых творожистых выделениях, которые могут иметь неприятный запах. Часто причиной молочницы становятся гормональные изменения, стресс, а также прием антибиотиков, которые нарушают баланс микрофлоры. Некоторые женщины замечают, что симптомы усиливаются перед менструацией или после полового акта. Важно помнить, что при первых признаках следует обратиться к врачу, так как самолечение может усугубить ситуацию. Поддержание иммунной системы и соблюдение гигиенических норм также играют ключевую роль в профилактике этого недуга.

Первые признаки молочницы у женщины
Среди первых признаков, указывающих на развитие молочницы, вызывающих беспокойство у женщин, выделяют:
- Сильное жжение и зуд в области наружных половых органов;
- Покраснение (гиперемия) наружных половых органов и влагалища;
- Обильные белые выделения из влагалища;
- Болезненное мочеиспускание;
- Дискомфорт во время полового акта.
Обычно симптомы начинают проявляться за неделю до менструации. Жжение и зуд усиливаются в теплой среде, например, после ванны, и могут мешать ночному сну. Появление белых выделений часто вызывает у женщин подозрения на заболевание и побуждает обратиться к врачу.
Последствия молочницы у женщин
В ситуации с молочницей стоит рассмотреть несколько сценариев:
- Пациентка вовремя начала лечение острого кандидоза. При правильном подходе и соблюдении всех указаний врача женщина может быстро избавиться от молочницы. Современные медикаменты отличаются высокой эффективностью и минимальными побочными эффектами.
- Острая молочница была лечена неправильно и с задержкой. Регулярное откладывание визита к врачу и несоблюдение его рекомендаций могут привести к переходу заболевания в хроническую стадию. В этом случае лечение становится значительно сложнее, а риск осложнений возрастает.

Осложнения хронической молочницы
Согласно статистике, хроническое течение болезни приводит к осложнениям в 70% случаев:
- Образование спаек в органах малого таза;
- Закупорка маточных труб из-за спаек;
- Бесплодие, вызванное непроходимостью труб или поражением яичников;
- Ослабление иммунной системы, что увеличивает риск частых инфекций;
- При беременности грибковые инфекции могут заразить плод в утробе;
- Распространение заболевания на другие органы малого таза, такие как мочевой пузырь и прямая кишка;
- Проникновение возбудителя в кровоток, что может привести к кандидозному сепсису.
Передаётся ли молочница мужчинам?
В норме мужской организм регулярно контактирует с теми же грибками, что и женский. Эти микроорганизмы присутствуют во влагалище большинства женщин, поэтому половые органы партнёра неизбежно сталкиваются с возбудителем молочницы. У мужчин также может развиваться кандидоз половых органов, проявляющийся и имеющий причины, схожие с женскими. Если у мужчины ослаблен иммунитет, есть сахарный диабет или другие факторы риска, он может легко заразиться молочницей. Более того, половой партнёр может передать в организм женщины значительное количество грибка, что может привести к развитию заболевания.
Таким образом, молочница может передаться мужчине только при наличии предрасполагающих факторов и несоблюдении основных правил личной гигиены. Мужчине проще избавиться от возбудителей на поверхности пениса, просто тщательно его промыв, в отличие от женщины. Кроме того, половой акт при наличии кандидоза является неразумным шагом, противоречащим рекомендациям врачей, и вряд ли принесёт удовольствие.
Как лечить мужа от молочницы?
Лечение партнёра или супруга проводится по аналогичной схеме, как и у женщин. В терапевтических целях применяются пероральные препараты, например, Пимафуцин в дозировке 100 мг четыре раза в день. Курс лечения длится 10 дней.
У мужчин кандидоз чаще всего протекает без выраженных симптомов. Если появляются заметные признаки заболевания, необходимо пройти обследование для выявления инфекций, ослабляющих иммунную систему. К таким заболеваниям относятся гепатиты В и С, ВИЧ-инфекция, СПИД и острый лейкоз.
Диагностика молочницы
Для точного диагноза и полной клинической картины врачу нужны не только результаты анализов, но и выводы, основанные на данных осмотра. При посещении гинеколога женщине следует подготовиться к ряду вопросов и предоставить максимально полную информацию, которая поможет специалисту.
Врач может задать следующие вопросы:
- Какие симптомы вас беспокоят? Опишите их подробно.
- Когда вы впервые заметили проявления заболевания?
- Изменялись ли симптомы с момента их появления? Если да, то как именно.
- Какого характера выделения? Обратите внимание на цвет, запах, количество и консистенцию – все детали важны.
- Что может усиливать симптомы? Если состояние ухудшилось, что этому способствовало? Когда и по каким причинам вы ощущаете облегчение?
- Были ли у вас подобные симптомы ранее?
- Лечились ли вы от заболеваний, передающихся половым путем?
- Какова ваша половая жизнь? Сколько у вас половых партнеров?
- Как вы предохраняетесь?
- Замечали ли вы у партнера выделения из полового члена?
- Какие лекарства вы принимали в последнее время? Если были назначены антибиотики, то какие именно?
- Сколько дней длятся ваши месячные? Какова их регулярность?
- Пользовались ли вы спринцеванием?
- Есть ли у вас хронические заболевания? Если были в прошлом, то какие?
После сбора всех необходимых данных врач проведет осмотр пациентки. Будет взят мазок с шейки матки и слизистой влагалища. Микроскопическое исследование мазка может выявить грибковые мицелии. Этот метод считается более информативным, так как позволяет определить тип грибковой инфекции, вызвавшей молочницу.
Чтобы выяснить, какой именно грибок стал причиной заболевания, проводится бактериальный посев мазка на специальные питательные среды. Это позволяет определить чувствительность выявленных колоний к противогрибковым препаратам. Также важен количественный аспект: небольшое количество колоний считается нормой для здоровой микрофлоры влагалища.
Исследования показывают связь молочницы с другими инфекциями, передающимися половым путем. В большинстве случаев кандидоз протекает в сочетании с другими заболеваниями, при этом симптомы молочницы могут быть скрытыми. За последние десятилетия наблюдается рост и широкое распространение таких инфекций. Поэтому врачи рекомендуют проводить дифференциальную диагностику молочницы, что позволит выявить наличие заболеваний, таких как гарднереллез, гонорея, трихомониаз, генитальный герпес и уреаплазмоз. Обращение к венерологу и сдача необходимых анализов помогут подтвердить или исключить наличие опасных инфекций и разработать правильный план лечения молочницы.
Комплексное обследование при хронической форме кандидоза может помочь выявить сахарный диабет. Первым симптомом этого серьезного заболевания часто является молочница. Если анализы показывают повышенный уровень сахара в крови, женщине рекомендуется обратиться к эндокринологу и следовать его рекомендациям.
Также важно участие гастроэнтеролога. Для эффективного лечения кандидоза может потребоваться УЗИ брюшной полости. Возможно, потребуется сдать анализ кала и проверить состояние кишечника. При наличии показаний назначаются ФГС и другие диагностические процедуры.
Если молочница приводит к осложнениям в мочевыводящей системе, необходимо обратиться к урологу, пройти обследование и сдать соответствующие анализы (УЗИ мочевого пузыря и почек, анализ мочи по Зимницкому, мазок из уретры).
Когда следует обязательно обратиться к гинекологу?
- Рецидивы кандидоза возникают более 4 раз в год.
- Лечение, продолжающееся неделю, не приносит результатов и не устраняет симптомы.
- Если после приема назначенных медикаментов возникает раздражение в области половых органов.
- При молочнице наблюдаются повышение температуры, слабость и боли внизу живота.
- Если кандидоз повторяется после завершения лечебного курса.
- Во время терапии появляются кровянистые и гнойные выделения, особенно коричневого цвета в середине курса лечения.
Чем лечить молочницу у женщин?
Медицинские препараты (лекарства, витамины, медикаменты) представлены исключительно для информационных целей. Мы настоятельно не рекомендуем их применять без консультации с врачом. Рекомендуем ознакомиться с материалом: «Почему нельзя использовать медицинские препараты без назначения врача?».
Если заболевание протекает в легкой форме и женщина вовремя обращается за медицинской помощью, специалисты предпочитают использовать местные средства. Это могут быть таблетки, кремы или свечи, которые вводятся во влагалище. Они быстро достигают нужного места и начинают действовать.
При первых симптомах
При первых признаках заболевания рекомендуется следовать следующей схеме терапии:
- Клотримазол в форме свечей — 14 дней.
- Флуконазол — таблетки в течение недели.
- После завершения двухнедельного курса лечения целесообразно пройти курс пробиотиков для восстановления нормальной интимной микрофлоры.
Видео: доктор Евдокименко «Как избавиться от молочницы у женщин и мужчин? Простые рекомендации, действенные средства»
При лёгкой форме
Для терапии кандидоза в легкой и неосложненной форме можно применять местные препараты:
- Клотримазол — используется в течение 14 дней, по одной вагинальной свече ежедневно.
- Миконазол — обладает противогрибковыми и антибактериальными свойствами. Рекомендуется вводить по одной свече во влагалище на ночь, курс лечения составляет 14 дней.
- Изоконазол — воздействует на проницаемость клеточных мембран грибков. Обладает противогрибковым эффектом и помогает устранить воспаление и зуд. Эффективен против грибков, устойчивых к другим антимикотикам. Вводится глубоко во влагалище по одной свече на ночь, курс — 3 дня.
- Фентиконазол.
- Флуомизин.
При хронической форме
При хроническом течении молочницы, помимо специализированных медикаментов, рекомендуется использовать антибактериальные и общеукрепляющие препараты:
- Флуконазол;
- Итраконазол;
- Пимафуцин — практически не токсичен и может применяться во время беременности. Эффективен против различных грибков. Свечи вводят во влагалище перед сном. Курс лечения составляет от 3 до 6 дней, продолжая терапию даже после улучшения состояния;
- Кетоконазол.
Особенности лечения во время беременности
Первые три месяца беременности считаются наиболее рискованным периодом для назначения медикаментов. В это время формируются органы и системы плода. Молочница в первом триместре встречается редко, так как уровень гормонов регулируется естественным образом, и защитные функции организма остаются на прежнем уровне.
Для терапии в первом триместре применяются следующие средства:
- Пимафуцин — 1 свеча на ночь в течение 6 дней.
- Бетадин — 1 свеча перед сном на протяжении 6 дней.
Во втором и третьем триместрах при молочнице разрешено использовать более активные противогрибковые препараты. Антимикотический курс может включать:
- Пимафуцин — 6 суппозиториев.
- Бетадин — 6 суппозиториев.
- Клотримазол — 7 суппозиториев.
- Гино-Певарил — 6 суппозиториев.
- Гинофорт — 1 влагалищный аппликатор.
Кандидоз во время беременности требует полноценного лечения. Улучшение состояния женщины с исчезновением симптомов обычно наблюдается через 2-3 дня после начала терапии. Однако это не означает, что лечение следует прекращать. Важно завершить полный курс, чтобы избежать обострений и повторного появления симптомов.
Необходимо использовать только противогрибковые препараты, так как средства широкого спектра действия могут привести к развитию других инфекций из-за полного уничтожения нормальной флоры.
Ускорить лечение молочницы помогает прием витаминов и минералов. Это способствует нормализации микрофлоры кишечника и укреплению иммунной системы. Рекомендуется употреблять пробиотики и витаминно-минеральные комплексы.
Противогрибковые препараты в гинекологии для местного применения:
| Название препарата | Активное вещество |
| Залаин (вагинальные свечи) | Сертаконазол |
| Кандизол, Антифунгол, Канестен, Клотримазол, Кандибене, Йенамазол 100, Кандид В6 | Клотримазол |
| Гино-певарил, Ифенек | Эконазол |
| Овулум, Гино-травоген | Изоконазол |
| Клион-Д 100, Гино-дактарин, Гинезол 7, Микогал | Миконазол |
| Ломексин | Фентиконазол |
| Пимафуцин | Натамицин |
| Полижинакс, Нистатин, Тержинан | Нистатин |
| Низорал, Ливарол, Микозорал, Кетоконазол, Ороназол, Бризорал, Веторозал | Кетоконазол |
Противогрибковые препараты для системного применения:
| Название препарата | Активное вещество |
| Флуконазол | Флюкостат, Микомакс, Эналаприл гексал, Дифлазон, Микосист, Микофлюкан, Дифлюкан, Цискан. |
| Итраконазол | Ирунин, Орунгал, Итразол, Орунит, Румикоз, Кандитрал. |
| Кетоконазол | Низорал, Микозорал, Фунгавис, Ороназол. |
| Таблетки Нистатин | |
| Таблетки Пимафуцин |
Побочные эффекты. Применение противогрибковых таблеток может вызывать нежелательные реакции, особенно со стороны пищеварительной системы. Возможны диарея, тошнота, метеоризм, боли в животе, нарушения функции печени и изменения вкусовых ощущений.
Среди побочных эффектов, связанных с нервной системой, отмечаются аллергические реакции, судороги, головные боли и головокружение. Наиболее серьезные осложнения могут возникнуть при использовании препаратов, содержащих Итраконазол.
Большинство пероральных противогрибковых средств противопоказано во время беременности и лактации, а также при заболеваниях печени, почечной недостаточности и повышенной чувствительности. Применение противогрибковых препаратов оправдано только в тех случаях, когда местное лечение оказывается недостаточным и требуется комплексный подход.
Что делать, чтобы предотвратить рецидив молочницы?
Для предотвращения повторного возникновения заболевания рекомендуется соблюдать следующие рекомендации:
- Применяйте системный противогрибковый препарат: 200 мг Итраконазола или 150 мг Флуконазола в первый день менструации в течение 6 месяцев.
- Используйте вагинальные суппозитории для местного лечения раз в неделю на протяжении 6 месяцев.
Диета при молочнице у женщин
При лечении молочницы важно исключить из рациона определенные продукты:
- блюда с высоким содержанием сахара;
- сладкие фрукты и соки из них;
- белый хлеб, макароны и изделия из муки, так как крахмал в них преобразуется в глюкозу, создавая благоприятную среду для бактерий;
- продукты, содержащие дрожжи, поскольку они могут увеличивать количество грибков в организме.
Полезны йогурты с высоким содержанием живых бактерий. Эти микроорганизмы могут стать серьезными конкурентами для грибков и усложнить их существование. Врачи отмечают, что регулярное употребление таких йогуртов может снизить риск развития кандидоза почти на 40%. Важно, чтобы йогурты были без добавления сахара.
Записаться на приём к гинекологу
Страница для записи к гинекологу ➤
| Запись к другим специалистам: |
| Акушер-гинеколог |
| Репродуктолог |
| Терапевт |
| Выбрать врача ➤ |
| Записаться на диагностику ➤ |
| Записаться на медицинскую процедуру ➤ |
Вопрос-ответ
Чем лечить молочницу быстро и эффективно?
Неосложненные формы лечатся короткими курсами местных антимикотиков (препараты имидазолового ряда — клотримазол, миконазол, или полиенов — нистатин, натамицин) или однократным приемом флуконазола 150 мг внутрь. Если вовремя острая молочница не вылечена, заболевание может стать хроническим.
Откуда заражаются молочницей?
Как происходит заражение? Да, болезнь заразна и передается от партнера к партнеру во время полового акта. Орально-генитальные ласки также могут способствовать инфицированию. В случае диагностирования кандидоза у одного партнера другой партнер также должен пройти курс лечения, чтобы не заболеть повторно.
Советы
СОВЕТ №1
Регулярно проходите гинекологические осмотры. Это поможет выявить молочницу на ранней стадии и предотвратить ее развитие. Не забывайте сообщать врачу о любых изменениях в вашем состоянии.
СОВЕТ №2
Обратите внимание на свой рацион. Употребление продуктов, богатых пробиотиками, таких как йогурт и кефир, может помочь поддерживать здоровую микрофлору влагалища и снизить риск возникновения молочницы.
СОВЕТ №3
Избегайте использования агрессивных моющих средств и ароматизированных гигиенических продуктов. Они могут нарушить естественный баланс микрофлоры и способствовать развитию грибковых инфекций.
СОВЕТ №4
Следите за уровнем стресса и старайтесь поддерживать иммунную систему. Стресс и ослабленный иммунитет могут способствовать развитию молочницы, поэтому важно находить время для отдыха и восстановления.